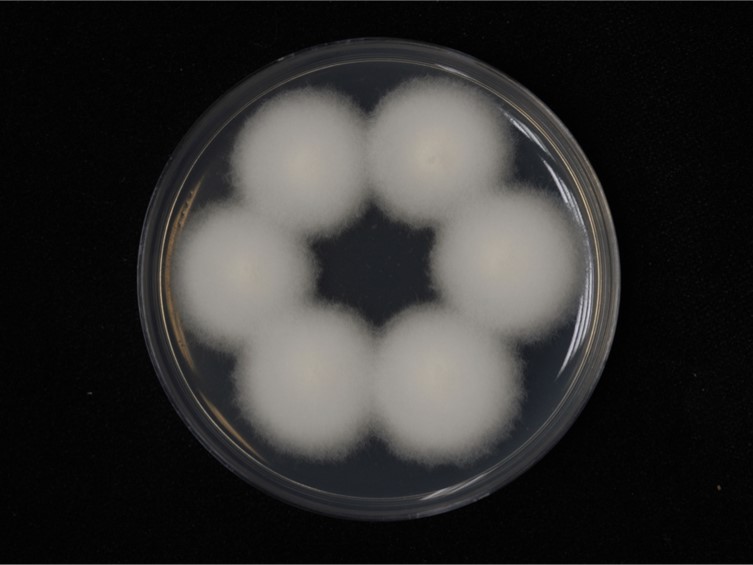

Holotype:
THAILAND, Ranong Province, Khlong Nakha Wildlife Sanctuary, 21 Apr. 1994, N.L. Hywel- Jones , R. Nasit, R. Promhan , S. Sivichai, S. Thienhirun, holotype NHJ 3531, neotype BBH 2649, ex-neotype living culture BCC 6839.
Habitat:
Underside of leaf.
Host:
Spider (Araneae).
Description:
Specimens were found on small hunting spiders attached to the underside of living leaves of forest plants.  Stroma of grayish mycelium completely covering the host. Synnemata numerous erect, clavate, grey, up to 3 mm high, 60-70 mm diam.
Stroma of grayish mycelium completely covering the host. Synnemata numerous erect, clavate, grey, up to 3 mm high, 60-70 mm diam.  Phialides in a monolayer, crowded, usually single or occasionally two or three on lateral basal cells, smoothwalled, cylindrical, 3.5-6.5 × 1.5-2 μm, tapering to a long, thin, neck, 2-2.5 × 0.5 μm.
Phialides in a monolayer, crowded, usually single or occasionally two or three on lateral basal cells, smoothwalled, cylindrical, 3.5-6.5 × 1.5-2 μm, tapering to a long, thin, neck, 2-2.5 × 0.5 μm.  Conidia catenate, one-celled, smooth-walled, hyaline, clavate, 3.5-5.5 × 1-1.5 μm.
Conidia catenate, one-celled, smooth-walled, hyaline, clavate, 3.5-5.5 × 1-1.5 μm.
Culture characteristics:
Colonies on PDA were slow-growing, 10–15 mm in 21 d at 22 °C, with a white aerial mycelium. There was no sign of sporulation but in culture it produced a pallid wine-red pigment.
Colonies on PDA were slow-growing, 10–15 mm in 21 d at 22 °C, with a white aerial mycelium. There was no sign of sporulation but in culture it produced a pallid wine-red pigment.
Reference:
Luangsa-ard JJ, Tasanathai K, Mongkolsamrit S, et al. (2007). Akanthomyces cinereus Hywel-Jones. In: Atlas of invertebrate-pathogenic fungi of Thailand Volume 1. National Center for Genetic Engineering and Biotechnology, National Science and Technology Development Agency: 11–12.
DOI: http://doi.org/10.3897/mycokeys.91.83091Species |
Strain |
Compound |
Pubchem CID |
Biological activity |
Reference |
|---|
|
Strain |
ITS | LSU | RPB1 | RPB2 | TEF1 |
|---|---|---|---|---|---|
| BCC 2191 | GQ250000 | GQ249971 | - | - | GQ250029 |
| NHJ 03510 | GQ249999 | GQ249970 | EU369048 | EU369070 | EU369009 |